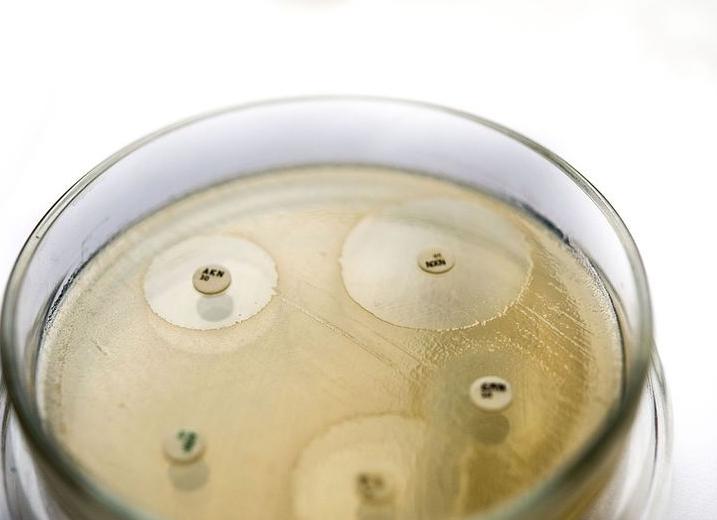
Чувствительный к антибиотикам что это такое

[Чувствительный к антибиотикам что это такое]
[Чувствительный к антибиотикам что это такое]
Что значит чувствителен к антибиотикам?
Очень часто, перед тем как назначить лечение и выписать соответствующие лекарственные препараты, врачи проверяют человека на чувствительность к антибиотикам. Делается это несколькими методами.
Итак, выявление чувствительности или сопротивляемости микроорганизмов к антибиотикам необходимо для назначения правильного метода лечения. Так, например, если у возбудителей инфекции наблюдается резистентность к определенному препарату, то лечение им просто не будет оказывать должного эффекта. Различают несколько форм сопротивляемости:
- чувствительные;
- умеренно чувствительные;
- устойчивые.
Чувствительные микроорганизмы погибают сразу же после введения небольших доз, а умеренно чувствительные – при определенных концентрациях. При этом устойчивые могут погибнуть только при взаимодействии с большим количеством антибиотика, который не может быть введен в организм, а, следовательно, необходимо искать альтернативный способ лечения и устранения заболевания.
Существует несколько способов определения чувствительности микроорганизмов к антибиотикам:
- метод последовательных разведений в жидкой питательной среде;
- метод диффузии в агар;
- ускоренный метод.
Чаще всего проба на чувствительность к антибиотикам проводится по методу определения в физиологической жидкости. В этом случае используется процесс обработки интегрированных пластин с различной концентрацией антибиотиков. Таким методом определяют больных раком, для того чтобы подтвердить или опровергнуть эффективность назначенных препаратов при химиотерапии.
Анализ на чувствительность к антибиотикам по диффузионному методу почти так же распространен, как и первый. При этом он дает лишь качественный ответ, есть или нет сопротивляемость.
Благодаря развитию микробиологических технологий, появились ускоренные методы диагностики, которые дают полную и развернутую информацию. Это очень важно при назначении лекарственных препаратов, а также, когда время не терпит, и следует как можно быстрее приступить к лечению.
Случается иногда так, когда результатов и вышеуказанных методов исследования недостаточно. В этом случае выводят минимальную бактерицидную концентрацию, которая способна уничтожить возбудителя инфекции, только происходит это в течение определенного промежутка времени.
Анализ на чувствительность к антибиотикам является обязательным при возникновении у врача подозрений, что заболевание пациента имеет бактериальную природу. Это связано с тем, что медики пытаются контролировать назначение данных препаратов, чтобы не стимулировать мутации и не вызывать резистентность у микроорганизмов.
Анализ на чувствительность к антибиотикам – это лабораторный способ выявления препарата, который будет оказывать наибольшее действие на патогенную флору в данном конкретном случае болезни.
На данный момент антибактериальная терапия применяется достаточно широко там, где она нужна, а также в тех случаях, когда это совсем не обязательно, для перестраховки от возможных осложнений. Например, после кесарева сечения, лапароскопических операций, удаления конкрементов из почек или мочеточников и т. д.
Фармацевтическая промышленность может предложить широкий выбор препаратов как в плане цены, так и в плане действенности. Для того чтобы не «тыкать пальцем в небо» и назначить эффективный антибиотик, нужно провести посевы на чувствительность.
Перед тем как врач подберет терапию, пациенту необходимо сдать некоторые анализы. Посев на чувствительность к антибиотикам назначается, если необходимо определить лекарство, которое в данном случае будет наиболее уместно. Чаще всего это исследование назначается для лечения заболеваний, передающихся половым путем, или ЗППП. Для детей же необходимость в определении антибиотика – это обязательное условие.
Кроме того, определение чувствительности нужно, чтобы избежать устойчивости бактерий к лечению. Если пациента недавно лечили антибиотиками, и теперь вновь необходим повторный курс, то требуется замена препарата. Это позволит использовать меньшие дозы лекарства и не вызывать мутации у возбудителя. В гнойных хирургических отделениях антибиотики меняют каждые два-три месяца.
Данный анализ необходим еще в том случае, если на основную группу антибиотиков у больного возникает аллергическая реакция.
Анализ мочи на чувствительность к антибиотикам, и не только ее, можно провести несколькими способами. Первый из них – это метод дисков. Проводят его следующим образом. В чашку Петри заливают агар, а когда он застынет, специальным инструментом наносят исследуемый материал. Затем по поверхности агара раскладывают бумажные диски, пропитанные антибиотиками. После чашку закрывают и ставят в термостат. Постепенно диск погружается в желатин, а антибиотик диффундирует в окружающее пространство. Вокруг бумаги образуется зона «подавления роста». Чашки проводят в термостате двенадцать часов, затем их вынимают и измеряют диаметр вышеуказанной зоны.
Второй способ – это метод Е-теста. Он похож на предыдущий, но вместо бумажных дисков используют полоску, которая на своем протяжении в разной степени пропитана антибиотиком. После двенадцати часов экспозиции в термостате чашку Петри достают и смотрят, в каком месте зона подавления роста соприкасается с полоской бумаги. Это будет наименьшая концентрация препарата, которая необходима для лечения заболевания.
Достоинством этих тестов является быстрота и простота их проведения.
Анализ на флору и чувствительность к антибиотикам можно провести и другим способом. Этот метод основан на последовательном уменьшении концентрации антибиотика (от максимальной до минимальной) с целью определить, в какой из пробирок прекратится сдерживание роста бактерий.
Сначала подготавливают растворы препарата. Затем их вносят в жидкую среду с бактериями (бульон или агар). Все пробирки на ночь (то есть 12 часов) помещаются в термостат при температуре 37 градусов, а утром проводят анализ получившихся результатов. Если содержимое пробирки или чашки Петри мутное, это свидетельствует о росте бактерий и, следовательно, неэффективности антибиотика в данной концентрации. Первая пробирка, в которой визуально не будет определяться рост колоний микроорганизмов, будет считаться достаточной концентрацией для лечения.
Это разведение препарата принято называть минимальной подавляющей концентрацией (МПК). Она измеряется в миллиграммах на литр или микрограммах на миллилитр.
Анализ на чувствительность к антибиотикам нужно уметь не только правильно сделать, но и грамотно расшифровать. Основываясь на получаемых результатах, все микроорганизмы делят на чувствительные, умеренно резистентные и резистентные. Для того чтобы различать их между собой, используются условные пограничные концентрации препаратов.
Эти значения не являются постоянными и могут изменяться в зависимости от приспосабливаемости микроорганизмов. Разработкой и пересмотром этих критериев поручено заниматься химиотерапевтам и микробиологам. Одной из официальных структур такого рода является Национальный комитет по клиническим лабораторным стандартам США. Разработанные ими стандарты признаны во всем мире для использования в оценке активности антибиотиков, в том числе для рандоминизированных многоцентровых исследований.
Различают два подхода к оценке результатов анализа на чувствительность к антибиотикам: клинический и микробиологический. Микробиологическая оценка ориентируется на распределение эффективных концентраций антибиотика, а клиническая — на качество антибактериальной терапии.
Анализ — определение чувствительности антибиотикам — назначается с целью выявить чувствительные и устойчивые микроорганизмы.
Чувствительными называются возбудители, которые поддаются лечению антибиотиками в средней терапевтической концентрации. Если достоверная информация о категории чувствительности микроорганизма отсутствует, то учитываются данные, полученные в условиях лаборатории. Они совмещаются со знаниями о фармакокинетике используемого препарата, и после синтеза данной информации делается вывод о восприимчивости бактерий к лекарству.
К резистентным, то есть устойчивым, микроорганизмам относятся те бактерии, которые продолжают вызывать заболевания даже при использовании максимальных концентраций лекарственных веществ.
Промежуточную резистентность устанавливают в том случае, если заболевание в процессе лечения может иметь несколько исходов. Выздоровление пациента возможно в случае использования высоких доз антибиотиков либо в случае прицельного накапливания лекарства в месте инфекции.
Анализ на микрофлору и чувствительность к антибиотикам определяет такой показатель, как минимальная бактерицидная концентрация, или МБК. Это самая низкая концентрация препарата, которая в лабораторных условиях вызывает элиминацию практически всех микроорганизмов в течение двенадцати часов.
Знание этого показателя врачи используют, когда назначают терапию не бактерицидными, а бактериостатическими лекарственными средствами. Или в случаях, когда стандартная антибактериальная терапия оказывается неэффективной. Чаще всего этот анализ заказывают для больных с бактериальным эндокардитом, остеомиелитом, а также при оппортунистических инфекциях.
Анализ на чувствительность к антибиотикам может проводиться с использованием биологических жидкостей:
— слюна;
— кровь;
— моча;
— сперма;
— грудное молоко.
Кроме того, для определения местной чувствительности производят забор мазков из уретры, цервикального канала и верхних дыхательных путей.
Для чего нужна чувствительность к антибиотикам
Чувствительность микроорганизмов к антибиотикам и химиопрепаратам – это свойство микроорганизмов реагировать на действие данных препаратов приостановкой размножения или гибелью. Каждый вид или близкая группа видов имеют характерный спектр и уровень природной чувствительности по отношению к определенному препарату или группе препаратов.
Для успешного проведения лечения антибиотиками, особенно в случаях хронической инфекции, необходимо предварительно определить степень чувствительности к антибиотикам микробов, вызвавших заболевание.
Мерой чувствительности микробов является минимальная концентрация препарата (мкг/мл), которая подавляет рост микробов на питательных средах в стандартных условиях постановки опыта. Выделяют 3 категории чувствительности-устойчивости микробов:
а) чувствительные подавляются при назначении обычных доз антибиотиков;
б) умеренно-устойчивые штаммы микробов подавляются при введении максимальных доз препарата;
в) устойчивые штаммы микробов не подавляются при введении в организм человека максимально допустимых доз.
В настоящее время для определения чувствительности микробов к антибиотикам применяют 3 метода: диффузии препарата в плотную питательную среду из бумажных дисков; серийные разведения в бульоне; в бактериологических анализаторах с количественной регистрацией результатов – определение минимальной ингибирующей концентрации.
В связи с широким распространением приобретенной устойчивости среди различных видов микроорганизмов необходимо перед назначением антибиотикотерапии провести выделение возбудителя заболевания в чистой культуре с последующим определением спектра чувствительности к антибиотикам. Обязательному исследованию на антибиотикочувствительность подлежат все микроорганизмы, выделенные из первично стерильных жидкостей, органов и тканей человека (кровь, спинномозговая жидкость, моча и т.д.). В бактериологической лаборатории МК ТюмГМА имеется бактериологический анализатор, что позволяет определить чувствительность микроорганизмов не только диско-диффузионным методом, но и минимальную ингибирующую концентрацию автоматизированным методом в анализаторе.
В.Н. Самикова,
Заведующая бактериологической лабораторией
Многопрофильной клиники ТюмГМА, к.б.н.
Чувствительность к антибиотикам
Что значит чувствительность к антибиотикам?
- чувствительные;
- умеренно чувствительные;
- устойчивые.
- метод последовательных разведений в жидкой питательной среде;
- метод диффузии в агар;
- ускоренный метод.
Статьи по теме:
| Фонофорез с гидрокортизоном
Физиотерапия и аппаратная косметология предлагает множество современных способов лечения и омоложения. Фонофорез с гидрокортизоном является одной из наиболее популярных и универсальных процедур. С какой целью его применяют, читайте в нашем новом материале. |
Если вас часто беспокоит болевой синдром в мышцах, суставах, спазмы или перенапряжение, задумайтесь о приобретении устройства, продуцирующего диадинамические токи. Наш материал подробно расскажет о данной физиопроцедуре и ее эффективности. |
| Амплипульстерапия – показания и противопоказания
Предлагаемая статья подробно описывает такую физиотерапевтическую процедуру, основанную на электрическом воздействии, как амплипульстерапия. Прочитайте показания к данному методу лечения, а также ознакомьтесь со списком болезней, исключающих использование переменного тока. |
Тюбаж печени в домашних условиях
Тюбаж печени обычно проводится в медицинских учреждениях. Однако данную процедуру можно при желании организовать и самостоятельно. Из нашей новой статьи вы сможете узнать, как правильно делается очистка печени в домашних условиях. |
Проба на чувствительность к антибиотикам
Что такое чувствительность к антибиотикам? Некоторые люди ошибочно предполагают, что это выражение указывает на аллергию к тому или иному препарату. Однако чувствительность микроорганизмов к антибиотику означает, что они погибают под его воздействием. Для того чтобы узнать, какой антибиотик эффективно справится с возбудителем того или иного заболевания, делается так называемый посев.
Каждый вид возбудителей обладает чувствительностью к определенному лекарственному средству, имеющему свой спектр действия, но из-за изменения экологии, появления новых антибактериальных препаратов болезнетворные микроорганизмы мутируют. Поэтому со временем может формироваться устойчивость к антибиотикам. В таком случае врачи производят замену препаратов при лечении.
Антибиотики способны спасти человеку жизнь, но они вовсе не безобидны. Неоправданное применение может нарушить работу кишечника, почек, сердца. Если не сделать тест на чувствительность, то может применяться совершенно не тот препарат, который необходим. Болезнь побеждена не будет и потребуется подбирать другое лекарственное средство. Антибиотики при длительном приеме почти всегда вызывают негативные побочные действия.
Вернуться к оглавлению
Как определяется чувствительность к препаратам
Чтобы определить чувствительность микроорганизма к антибиотику, нужно сделать забор биоматериала. Процесс проведения данной процедуры зависит от локализации возбудителя. Образцами биоматериала для посева могут стать:
- кровь;
- урина;
- слюна;
- грудное молоко;
- сперма;
- секрет простаты;
- мазок из носа, влагалища, уретры.
При ангине берется мазок из налета, который образуется на миндалинах. Ангина вызывается грибками, вирусами, бактериями (стрептококками, стафилококками и т.д.). Ввиду такого разнообразия причин, по которым возникает недуг, для эффективного лечения требуется провести процедуру чувствительности на каждый вид возбудителя болезни.
Существует три способа определения чувствительности к антибиотикам: при помощи бумажных дисков, с помощью серийного разведения лекарства в питательной среде или серийного разведения антибиотика в агаризованной среде. Способ с бумажными дисками основан на диффузии (рассеивании) препарата в специальной среде. Концентрация средства подбирается так, чтобы диаметр зон задержки роста микроорганизмов составлял 28 — 32 мм.
Исследуемые формы бактерий или вирусов высеивают на поверхности агаризованной среды в специальном лабораторном сосуде (чашка Петри). С помощью стерильного прибора на поверхности с микроорганизмами размещают бумажные диски на одинаковом расстоянии, предварительно пропитанные раствором антибиотика. Сосуды держат в термостате при нужной температуре, чтобы был возможен рост.
Если бактерии чувствительны к раствору, то вокруг дисков наблюдается зона задержки роста бактерий. Диаметр такой зоны будет соответствовать степени чувствительности бактерий к лекарственному препарату.
Вернуться к оглавлению
Другой метод проверки чувствительности
Определить чувствительность к антибиотикам можно при помощи его разведения в жидкой питательной среде. Для проведения процедуры требуется:
- раствор необходимых антибиотиков;
- специальная питательная среда с оптимальными условиями роста;
- образцы возбудителей заболевания.
Этот тест начинают с того, что в стерильные пробирки помещают по 2 мл питательной среды. В первый сосуд добавляют 2 мл лекарственного раствора и хорошо перемешивают полученный состав. Дальше берут 2 мл этого состава и помещают во вторую пробирку, при этом перемешивая раствор. Из второго сосуда в третий и т.д. Из предпоследней лабораторной посудины 2 мл антибиотика удаляют. При соблюдении такого способа разведения в пробирках должно находиться 2 мл раствора, но концентрация антибиотика в каждой последующей пробирке будет слабее.
В последней пробирке антибиотик не содержится. Она нужна для контроля роста возбудителя. После проделанных манипуляций с питательной средой и раствором лекарства в каждую пробирку добавляют 0,1 мл клеток. В каждом 1 мл должно содержаться 104 — 105 клеток. После этого пробирки тщательно взбалтывают и оставляют на 20 часов в необходимой для роста температуре. Результаты исследуют сначала по просмотру содержимого в пробирках. Определение степени помутнения показывает, каков рост бактерий.
В пробирке с наименьшей концентрацией лекарства, в которой не происходит рост микроорганизмов, содержимое будет прозрачным. Это значит, что рост возбудителя болезни сдержан, но не уничтожен. Следующим шагом является посев содержимого, которое не помутнело, в полноценную питательную среду. Если не наблюдается рост микроорганизмов, то это значит, что бактерии полностью погибли под воздействием данного лекарственного препарата.
Вернуться к оглавлению
Третий способ проверки на чувствительность
Реакция препаратов в агаризованной среде
Следующая проба на чувствительность к антибиотику заключается в методе серийного разведения препарата в агаризованной среде. Такой способ имеет преимущества перед другими, потому что есть возможность в одной процедуре установить чувствительность нескольких видов организмов к лекарственному средству. В стерильную агаризованную среду помещают лекарственный раствор с антибактериальным препаратом, взбалтывают и помещают в стерильные лабораторные посудины.
Как только агар застынет, дно чашек Петри разделяют на стора маркером. Каждый исследуемый микроорганизм засевают раствором с разной концентрацией лекарства. Дальше чашки Петри с содержимым помещают на время от 40 до 72 часов в термостат с нужной температурой для размножения возбудителей. Полученные результаты расшифровывают в зависимости от роста бактерий или его отсутствия по сравнению со средой в контрольной посудине. Чувствительность к антибиотику учитывается, если рост возбудителя полностью подавлен.
Благодаря развитию медицины и новых технологий существуют ускоренные методы определения чувствительности микроорганизмов к антибиотикам. Такие способы также помогают определить информацию о чувствительности возбудителей к лекарству. Эти методы применяются, когда требуется немедленно начать лечение антибактериальными средствами.
Вернуться к оглавлению
Обработка клинических данных
После проведения лабораторных исследований выделяют 3 категории чувствительности микроорганизмов к лекарствам:
- чувствительные;
- умеренно чувствительные;
- устойчивые.
Возбудитель считается чувствительным к антибиотику, когда его рост прекращается при терапевтической дозе лекарства в крови.
Умеренно чувствительные возбудители — это те, для уничтожения которых требуется максимальная доза препарата. Под устойчивостью бактерий подразумевается, что антибиотики определенной группы не смогут победить заболевание даже при высоких дозах. При таком явлении требуется искать другой подходящий препарат.
К настоящему времени нет способов, с помощью которых можно абсолютно точно спрогнозировать терапевтический эффект лекарств данной группы в лечении инфекционных или вирусных недугов. Но те способы, что практикуются сегодня для определения чувствительности к антибиотикам, помогают выбрать правильный ориентир при назначении лечебной терапии.